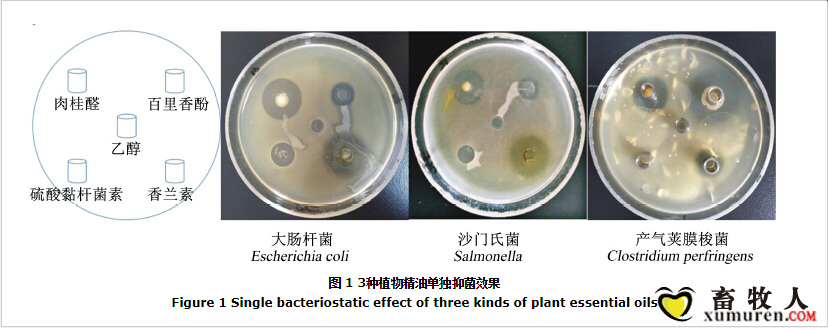
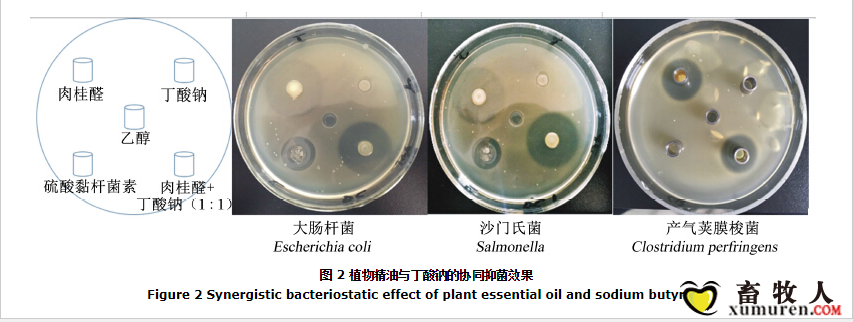
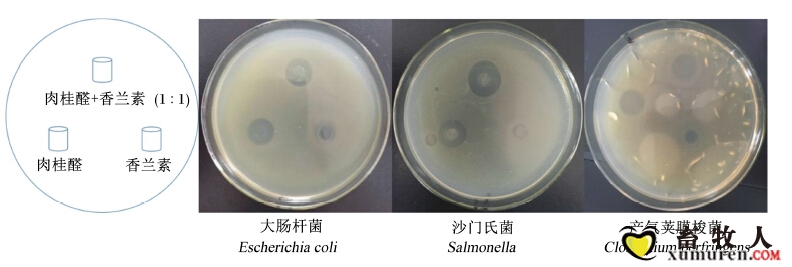

本帖最后由 樱桃小丸子 于 2019-11-22 11:52 编辑
摘要: 本试验旨在研究植物精油与丁酸钠的体外协同抑菌效果。采用牛津杯法,测定肉桂醛、百里香酚和香兰素对于4种细菌(大肠杆菌、沙门氏菌、产气荚膜梭菌、乳酸菌)的抑菌效果。并将单方和复合植物精油分别与丁酸钠复配,测定其抑菌效果。结果表明:3种植物精油均对大肠杆菌、沙门氏菌、产气荚膜梭菌有明显抑制作用,但对乳酸菌无抑制作用,在相同浓度下,抑菌效果为肉桂醛>香兰素>百里香酚。肉桂醛与香兰素复合植物精油抑菌效果优于单方植物精油,当肉桂醛与香兰素的质量比为6:1时抑菌效果最佳。丁酸钠没有显示出抑菌作用,但丁酸钠与植物精油复合可明显降低植物精油的使用量。综上所述,不同植物精油的复合具有协同作用,植物精油和丁酸钠之间也存在着协同作用。
关键词: 植物精油 丁酸钠 协同抑菌效果 最小抑菌浓度 抗生素由于药物的残留、病原菌的耐药性等问题而逐渐被限制在饲料中使用。因此,寻找绿色安全的抗生素替代物成为当前动物营养研究的热点。Fang等[1]报道,将1 g/kg刺五加精油添加到21日龄断奶仔猪的饲粮中,仔猪肠道大肠杆菌、金黄色葡萄球菌和沙门氏菌的数量显著降低。Michiels等[2]研究表明,百里香酚能够显著提高仔猪空肠和盲肠中乳酸杆菌的数量,降低空肠中的厌氧菌、梭菌和链球菌的数量。丁酸钠在维持细胞的分化和结肠上皮的完整性、提高动物生产性能方面发挥着重要作用。Kotunia等[3]在3日龄仔猪人工乳中加入丁酸钠,发现丁酸钠使空肠和回肠绒毛长度和黏膜厚度增加。Manzanilla等[4]研究表明,饲粮中添加丁酸钠可以增加断奶仔猪回肠杯状细胞的数量。李丹丹等[5]研究表明,饲粮中添加丁酸钠能促进断奶仔猪的生长和免疫器官发育,提高血清免疫球蛋白的含量,刺激机体肠道黏膜分泌免疫球蛋白A,提高其免疫功能。王纯刚[6]研究发现,在饲粮中添加丁酸钠可减少仔猪受轮状病毒感染的应激反应。植物精油具有抑菌效果,可抑制肠道致病菌的增殖,进而促进动物健康生长。目前对于植物精油、丁酸盐的研究大多是对其单一特性的分析,而对于植物精油与丁酸盐的协同作用方面的研究相对较少。本试验通过体外抑菌试验寻求抑菌效果最好的植物精油,并且研究植物精油与丁酸钠的协同作用,旨在为进一步开发新型绿色饲料添加剂提供理论依据。 1 材料与方法
1.1 试验材料
肉桂醛(淡黄色液体)、百里香酚(无色半透明结晶)、香兰素(白色粉末)、丁酸钠(白色粉末),均由浙江万方生物科技有限公司提供,试验前置于4 ℃冰箱、避光条件下保存。 大肠杆菌(ATCC 25922)、沙门氏菌(CICC 21913)、产气荚膜梭菌(ATCC13124)均购自广东省菌种保藏中心,乳酸杆菌(ATCC 7469)购自中国工业微生物菌种保藏中心。 1.2 试验设计1.2.1 抑菌试验
抑菌试验采用牛津杯法。培养基表面放5个灭菌牛津杯,分别加入3种精油(百里香酚、肉桂醛、香兰素,添加量均为16 mg/mL),并加入95%乙醇做空白对照,加入硫酸黏杆菌素(1 280 μg/mL)做阳性对照。每个菌种做3个平行,放入37 ℃的生化培养箱中培养24 h。 1.2.2 最低抑菌浓度(minimal inhibitory concentration,MIC)及复合植物精油抑菌试验
通过牛津杯筛选获得初步抑菌效果较佳的植物精油,采用梯度稀释法测定植物精油的MIC。 复合植物精油由肉桂醛和香兰素组成,抑菌试验中肉桂醛和香兰素按梯度比例(6:1、4:1、2:1、1:1、1:2、1:4、1:6,质量比)进行复合制剂的配制,并寻求最佳的比例。 1.2.3 植物精油与丁酸钠的协同抑菌试验
按照1.2.1 的试验方法,在灭菌牛津杯分别加入植物精油(16 mg/mL)、丁酸钠溶液(2.2 mg/mL)、植物精油+丁酸钠(1:1,质量比),并以95%乙醇做空白对照,以硫酸黏杆菌素(1 280 μg/mL)做阳性对照。每个菌种做3个平行,然后放入37 ℃的生化培养箱中恒温培养24 h。 1.3 数据处理
数据采用Excel 2003进行统计分析,以平均值±标准差表示。 2 结果与分析
2.1 3种植物精油单独抑菌效果
由表 1和图 1可知,肉桂醛和香兰素对大肠杆菌、沙门氏菌和产气荚膜梭菌都有很强的抑制作用。此外,硫酸黏杆菌素是肠道细菌敏感的抗生素之一,对于大肠杆菌、沙门氏菌和乳酸菌都具有敏感性,可抑制其增殖。

2.2 植物精油与丁酸钠的协同抑菌效果
由表 2和图 2可知,肉桂醛、肉桂醛与丁酸钠1:1混合对大肠杆菌、沙门氏菌和产气荚膜梭菌的抑制效果大致相同,表明丁酸钠与植物精油复配可以减少至少50%的精油用量。
2.3 不同植物精油的MIC
由表 3和图 3可知,肉桂醛对产气夹膜梭菌的抑菌作用最强,其次为沙门氏菌,对大肠杆菌的最低抑菌浓度为312.50 μg/mL;香兰素对产气夹膜梭菌的抑菌作用较强,对大肠杆菌和沙门氏菌的最低抑菌浓度均为625.00 μg/mL。肉桂醛与香兰素1:1复合时的抑菌效果优于单独使用香兰素。

2.4 复合植物精油的MIC
由表 4和图 4可知,在复合植物精油中,抑菌作用最强的是肉桂醛与香兰素6:1的配比,肉桂醛所占比例越大,抑菌效果越佳。
2.5 复合植物精油与丁酸钠的协同抑菌效果
由表 5和图 5可知,肉桂醛与香兰素的复合植物精油和复合植物精油与丁酸钠1:1、1:2、1:3混合物对大肠杆菌、沙门氏菌和产气荚膜梭菌的抑制效果大致相同,表明复合植物精油和丁酸钠之间也存在协同作用,在保持相同抑菌效果的前提下,丁酸钠能够减少75%的复合植物精油的使用量。


3 讨 论
某些植物精油具有较强的抑菌效果已经被很多报道和研究所证实,汪中兴等[7]检测了3种可饲植物精油(肉桂油、牛至油和百里香油)在一定配比下对猪源产肠毒素大肠杆菌K88和霍乱沙门菌A72的体外抑菌作用,结果表明抑菌效果为:肉桂油>牛至油>百里香油。张赟彬等[8]通过对植物精油的主要化学成分进行分析总结,发现许多植物精油的成分中包含苯环或者共轭双键结构,例如肉桂醛、香兰素以及柠檬醛等,这种结构通过结合微生物细胞膜表面的离子通道蛋白,从而改变细胞膜的通透性,加速菌体代谢致使细菌死亡。本试验的研究结果发现肉桂醛表现出很强的抑菌作用,香兰素的抑菌作用次之,百里香酚最弱。 现有对于植物精油的协同性的研究大致体现在2个方面,其中一方面为不同植物精油之间的协同。复合植物精油由于含有不同组分,能够多途径、多靶位发挥协同效应,整体的作用效果一定程度上强于单方植物精油。Imming等[9]枚举了植物精油进入机体后其所有可能的靶作用点,其中有代谢酶、基质、转运载体、蛋白质、受体、细胞因子、DNA/RNA等。Galindo等[10]研究发现,植物精油中的多酚类物质,虽然其本身的物理特性较为模糊,却能够通过提高主要活性物质的溶解度和吸收率来增强整体的作用效果。而醛类物质,能够穿透细胞膜,与细胞质内的蛋白质结合,从而抑制关键酶的活性,达到抑菌的效果[11]。例如,Roldán-Gutiérrez等[12]的研究发现植物精油的复合效应能够抵抗大多数致病细菌,如单增李斯特菌,这种菌对所有单一植物精油都有一定的耐受性,复合植物精油能够更好地抑制其生长,同时多种植物精油复合可以减少植物精油的添加量,并增强其抑菌效果。Bassolé等[13]研究表明,相比于单独使用香芹酚(瓦解细胞外膜)和百里香酚(结合菌体蛋白)的抑菌效果,综合了两者的野蔷薇精油的抑菌效果更佳。Bozkurt等[14]研究发现,将含有香芹酚、百里酚、桉树脑和柠檬烯的植物精油混合物添加到蛋鸡的基础饲粮中,能够有效缓解应激,降低死亡率。Arczewska-Wlosek等[15]指出,混合植物精油(含百里香酚、大蒜精油)能够缓解肉鸡染艾美尔球虫病的病情。Rahimi等[16]研究发现,百里香酚、紫雏菊和大蒜精油的混合物可显著减少肉仔鸡回肠、盲肠中大肠杆菌的数量。目前发现的植物精油中有协同增效作用的成分很多,常见的复配组合有肉桂醛和香兰素、紫苏醛和蓼二醛等,通过复配都可以降低各自的MIC[17]。植物精油在动物肠道健康的保健和治疗上的应用更为常见,刘容珍等[18]认为选对合适的植物精油组合,可以用最少的剂量达到最大的收益,同时能够减轻或消除潜在的副作用。因此,研究植物精油及其主要成分之间抑菌作用的协同性有着重要的科学意义。本试验首次发现肉桂醛和香兰素的配比为6:1时对大肠杆菌、沙门氏菌和产气荚膜梭菌的抑制效果最强。 植物精油的协同性研究的另一方面是将复合植物精油和其他抑菌物质联用,从而提高其抑菌活性。Bassolé等[13]在野蔷薇精油中发现除主要抑菌物质(香芹酚和百里香酚)外,薄荷酮、桉树脑等也在强化整体的抑菌效果。王继凤等[19]发现,丁酸钠在一定程度上,在不影响抑菌效果的作用下,能够减少一部分抗生素的用量,且与抗生素存在协同效应。王帆等[20]的体外试验表明,复合植物精油与单宁酸进行复配能够对5种常见致病菌(金黄色葡萄球菌、大肠杆菌、铜绿假单胞菌、肠炎沙门氏菌和单增李斯特菌)均产生较强的抑制作用,且复配后各成分的MIC都有降低。找到合适的配比,能够使得复合植物精油的抗菌活性增强,并且能够减少的精油的使用量。李凯年[21]研究发现,饲料添加剂Natesse(含有丁酸钠和组合精油)可以减少肉鸡卵囊的排泄。齐胜利[22]的研究认为,在植物精油中添加丁酸有助于增强植物精油中活性成分的抗菌作用。Jerzsele等[23]试验也表明,在肉鸡的饲粮中添加香精油或者是丁酸钠与植物精油的混合物后小肠绒毛长度/隐窝深度值得到极其显著提高,并且产气荚膜梭菌的数量显著减少。本试验结果表明,复合植物精油和丁酸钠之间存在协同作用,丁酸钠的加入能够减少75%的复合植物精油(肉桂醛与香兰素以6:1的质量比复合)的使用量,同时淡化了植物精油的浓郁气味。 4 结 论
肉桂醛和香兰素组成的复合植物精油对大肠杆菌、沙门氏菌和产气荚膜梭菌的抑制作用比单方植物精油更强,2种单方植物精油之间存在协同效应,最适配比为6:1。丁酸钠与植物精油之间存在协同作用,并且能够减少75%的复合植物精油(肉桂醛与香兰素以6:1的质量比复合)的使用量。
作者:韩乾杰, 张玲玲, 陈敏, 李慧, 范小燕, 杨彩梅 参考文献:略
转自:动物营学报
声明:本篇图文版权归原作者所有,若有侵犯到您的权利,请及 时后台留言或联系我们删除。
| 